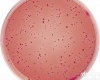
FS-008-0361 <em>弧菌</em>显色琼脂<em>培养基</em>平板

(二)校正pH值:将称量好的培养基各种成分放入容器内,标记划线,加热溶解,补充水分,测定酸碱度,常用pH6.8~8.0的精密试纸或酸度计测定。用1N NaOH和1N HCl调节pH值到适宜范围内。
(五)灭菌:培养基的灭菌,常用高压蒸汽灭菌法。一般微生物的营养细胞在水中煮沸后即被杀死,但细菌的芽胞有较强的抗热性,须经高压蒸汽灭菌才能达到彻底灭菌的目的。根据蒸汽温度随压力升高而上升的原理,即压力越大,蒸汽温度就越高。因此,在同一温度条件下,采用高压蒸汽灭菌比干热灭菌法效果要好。而且在湿热情况下,菌体吸收水分后,其蛋白质易于凝固变性,因为蒸汽的穿透力强,杀菌效果好。
小鼠C型钠尿肽(CNP)elisa试剂盒,96T/48T
升麻素苷标准品,cas:80681-45-4对照品
bs-13554R,锌指蛋白BED4抗体|ZBED4抗体价格
bs-4246R,核因子活化T细胞胞浆蛋白2抗体|NFAT1抗体价格
铁离子测试盒
盐酸对照品/标准品
重组人 PLA2G2D/Phospholipase A2 IID 蛋白(Fc 标签)/12479-H02H
bs-0327R-HRP,辣根过氧化物酶标记的兔抗牛IgM|Rabbit Anti-Bovine IgM/HRP抗体价格
bs-3884R,谷胱甘肽过氧化酶4抗体|GPX4抗体价格
大鼠粒细胞集落刺激因子(G-CSF)ELISA检测试剂盒说明书
松塔对照品/标准品
多巴标准品,cas:59-92-7对照品
bs-5430R,磷酸化丝裂原活化蛋白激酶激酶5抗体|phospho-MEK5(Ser311+Thr315)抗体价格
CAS:18674-16-3,泽泻醇A-24-醋酸酯标准品/对照品
bs-1787R,GATA结合蛋白6抗体|GATA6抗体价格
大鼠肿瘤坏死因子相关凋亡诱导配体1(TRAIL-R1)ELISA试剂盒,96T/48T
CM0069T/CM1164T/伊红美蓝琼脂(Levine)培养基厂家
利托奈韦中间体 MTV厂家|CAS号201409-23-6
异补骨脂素标准品|对照品,cas:523-50-2
人YZ素(INH)ELISA试剂盒,96T/48T
重组食蟹猴 CD160 蛋白/90224-CCCH
bs-6886R,WD重复膜蛋白61抗体|WDR61抗体价格
bs-0369M-PE-Cy7,PE-Cy7标记的小鼠抗兔IgM|Mouse Anti-Rabbit IgM/PE-Cy7抗体价格
胰蛋白酶-EDTA溶液(0.05%:0.02%)
bs-5389R,磷酸化组蛋白去乙酰化酶2抗体|phospho-HDAC2 (Ser394)抗体价格
氟甲睾酮厂家|CAS号76-43-7
杠柳/对照品
印度獐芽菜对照品/标准品
CAS:30462-34-1,茶黄素-3-没食子酸标准品/对照品
人胆囊收缩素/缩胆囊素八肽(CCK-8)ELISA试剂盒,96T/48T
阿奇霉素杂质J对照品/标准品
CAS:112-84-5,芥酸酰胺价格
银杏内脂M标准品,cas:15291-78-8对照品
川西獐牙菜对照品/标准品
重组人 ALDOB/Aldolase B 蛋白 GST 标签/13207-H09E
CAS:56293-29-9,苦豆碱标准品/对照品
CAS:62956-48-3,戈米辛G标准品/对照品
人17羟孕酮(17-OHP)ELISA试剂盒,96T/48T
CAS:4085-31-8,磷酸哌喹 现货供应
胰蛋白酶-EDTA溶液(0.05%:0.02%,含酚红)
人甲状腺结合球蛋白(TBG)ELISA检测试剂盒说明书
bs-0297M-PE-CY5,PE-CY5标记的小鼠抗人IgG|Mouse Anti-human IgG/PE-CY5抗体价格
CAS:52613-28-2,去乙酰车叶草苷酸甲酯标准品/对照品
人糖原磷酸化酶同工酶MM(GP-MM)ELISA试剂盒,96T/48T